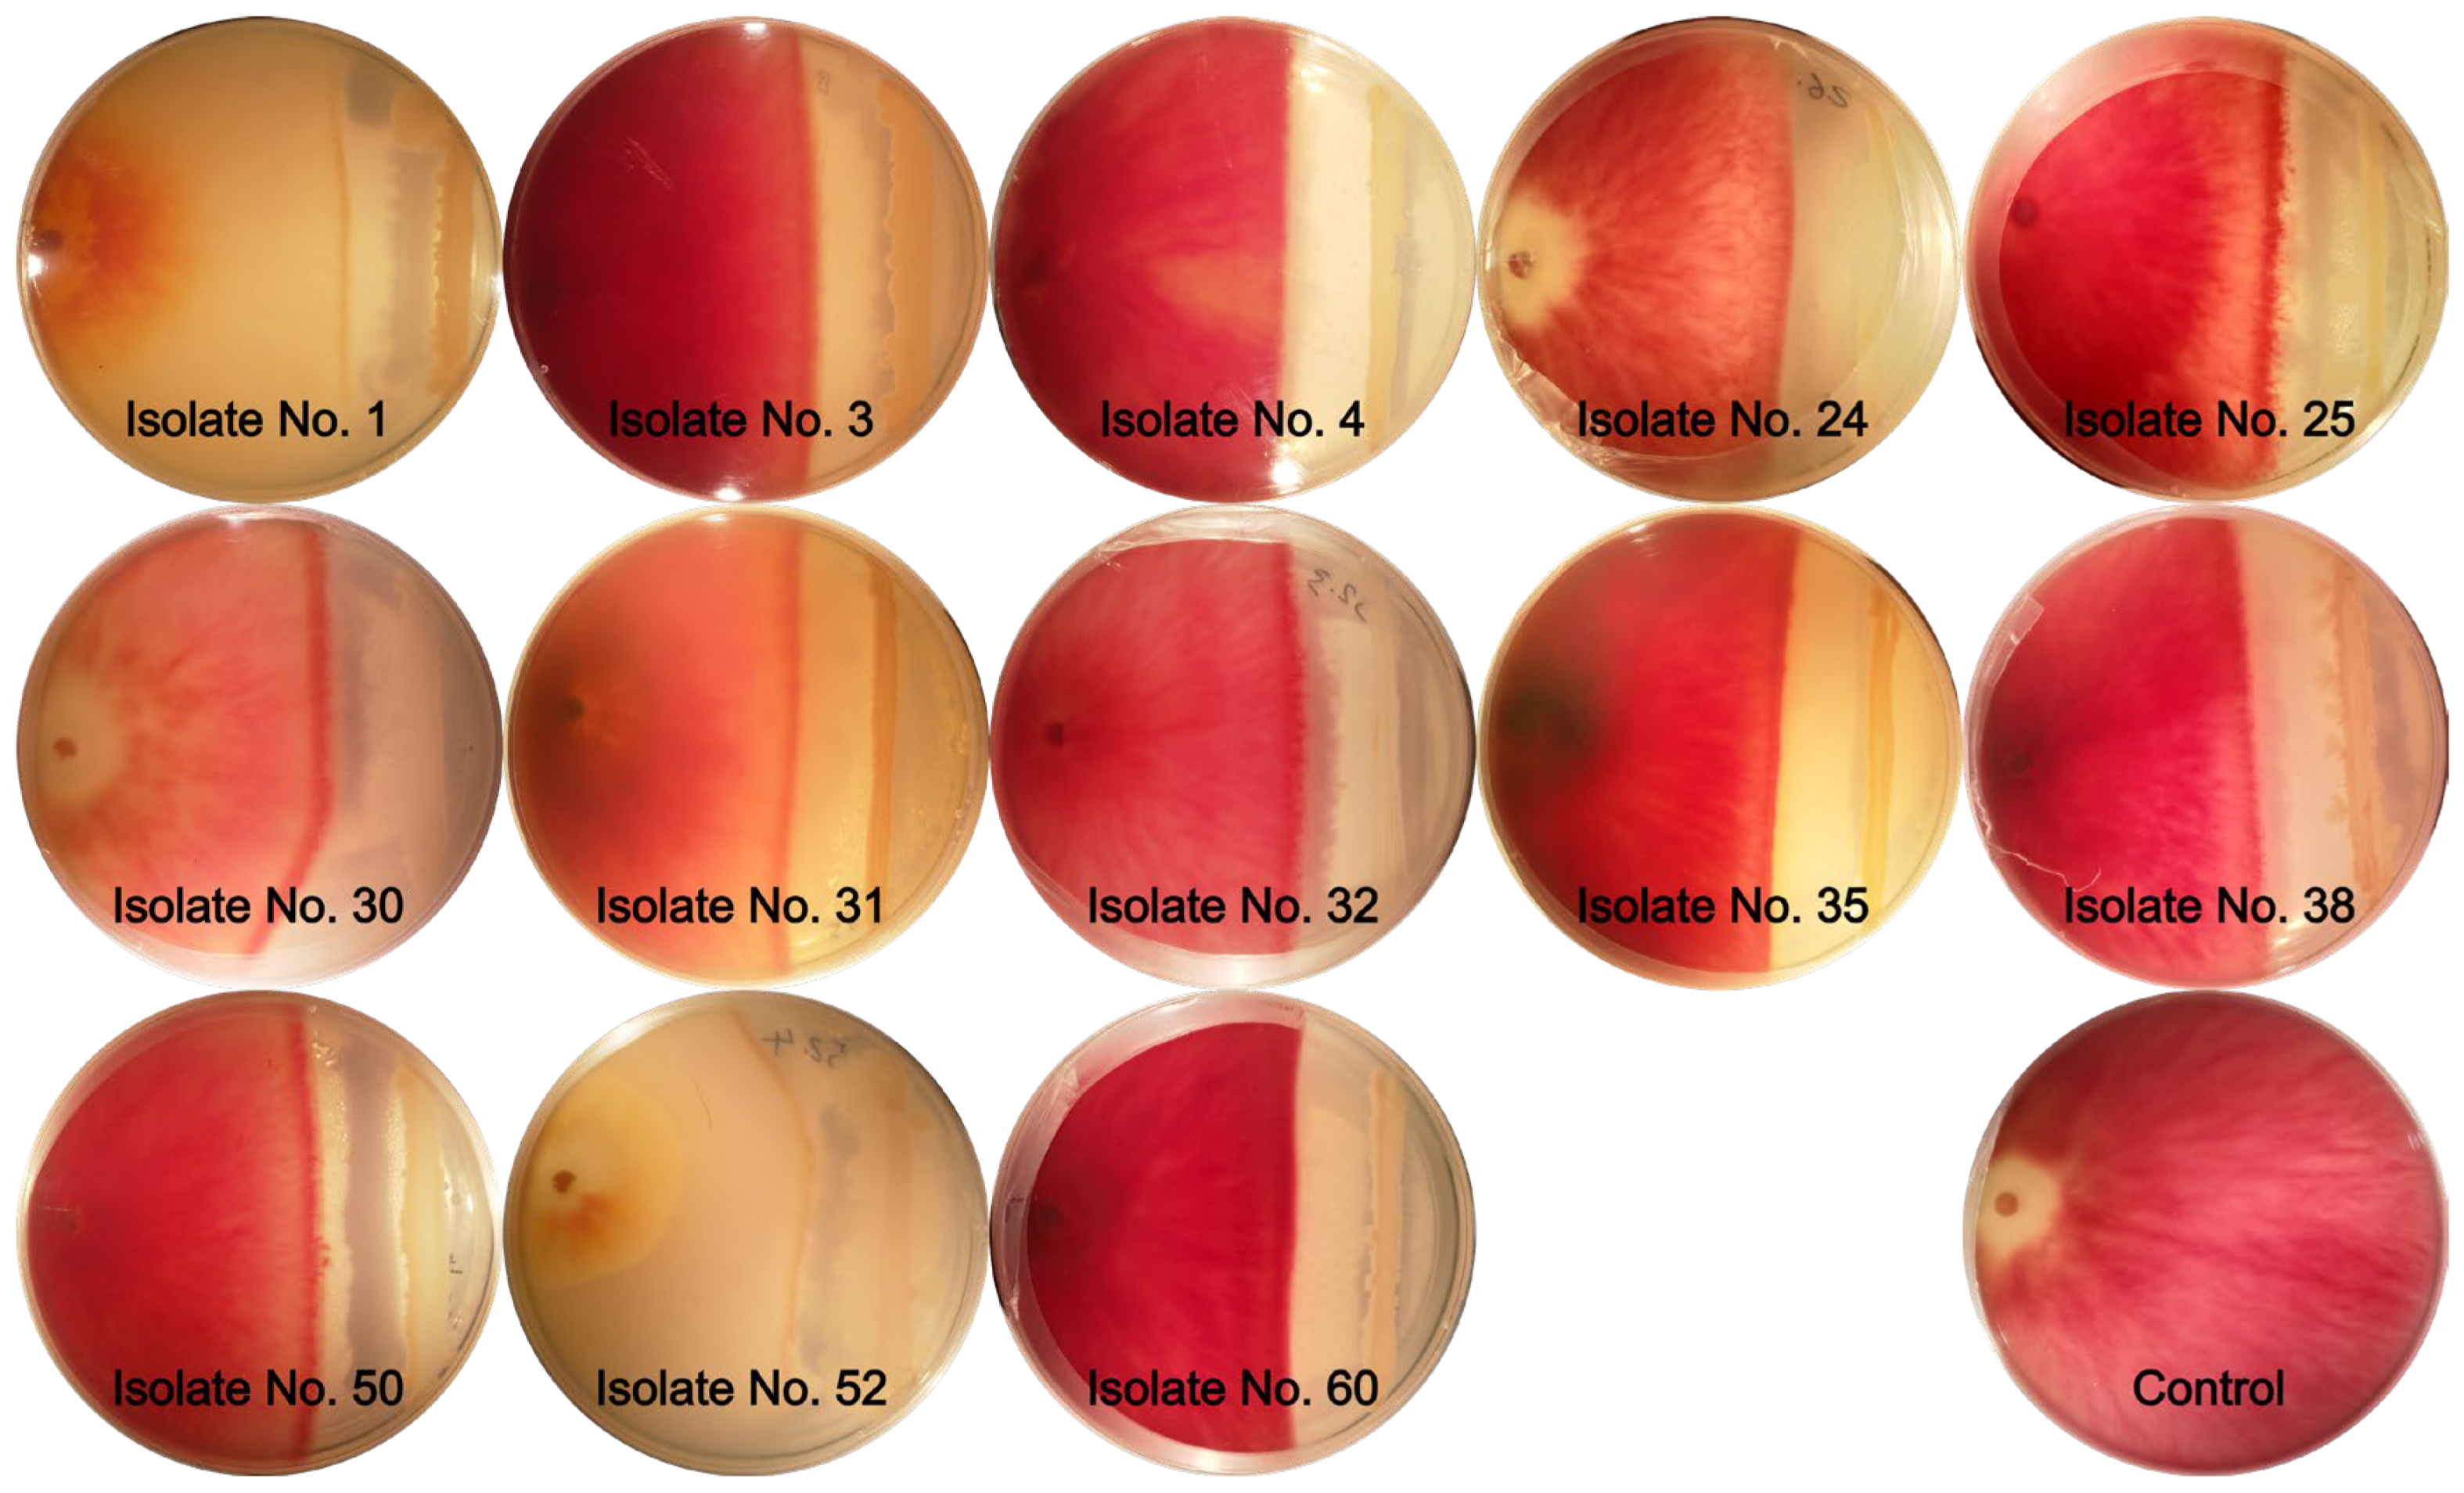
Agronomy 14 02912 g001
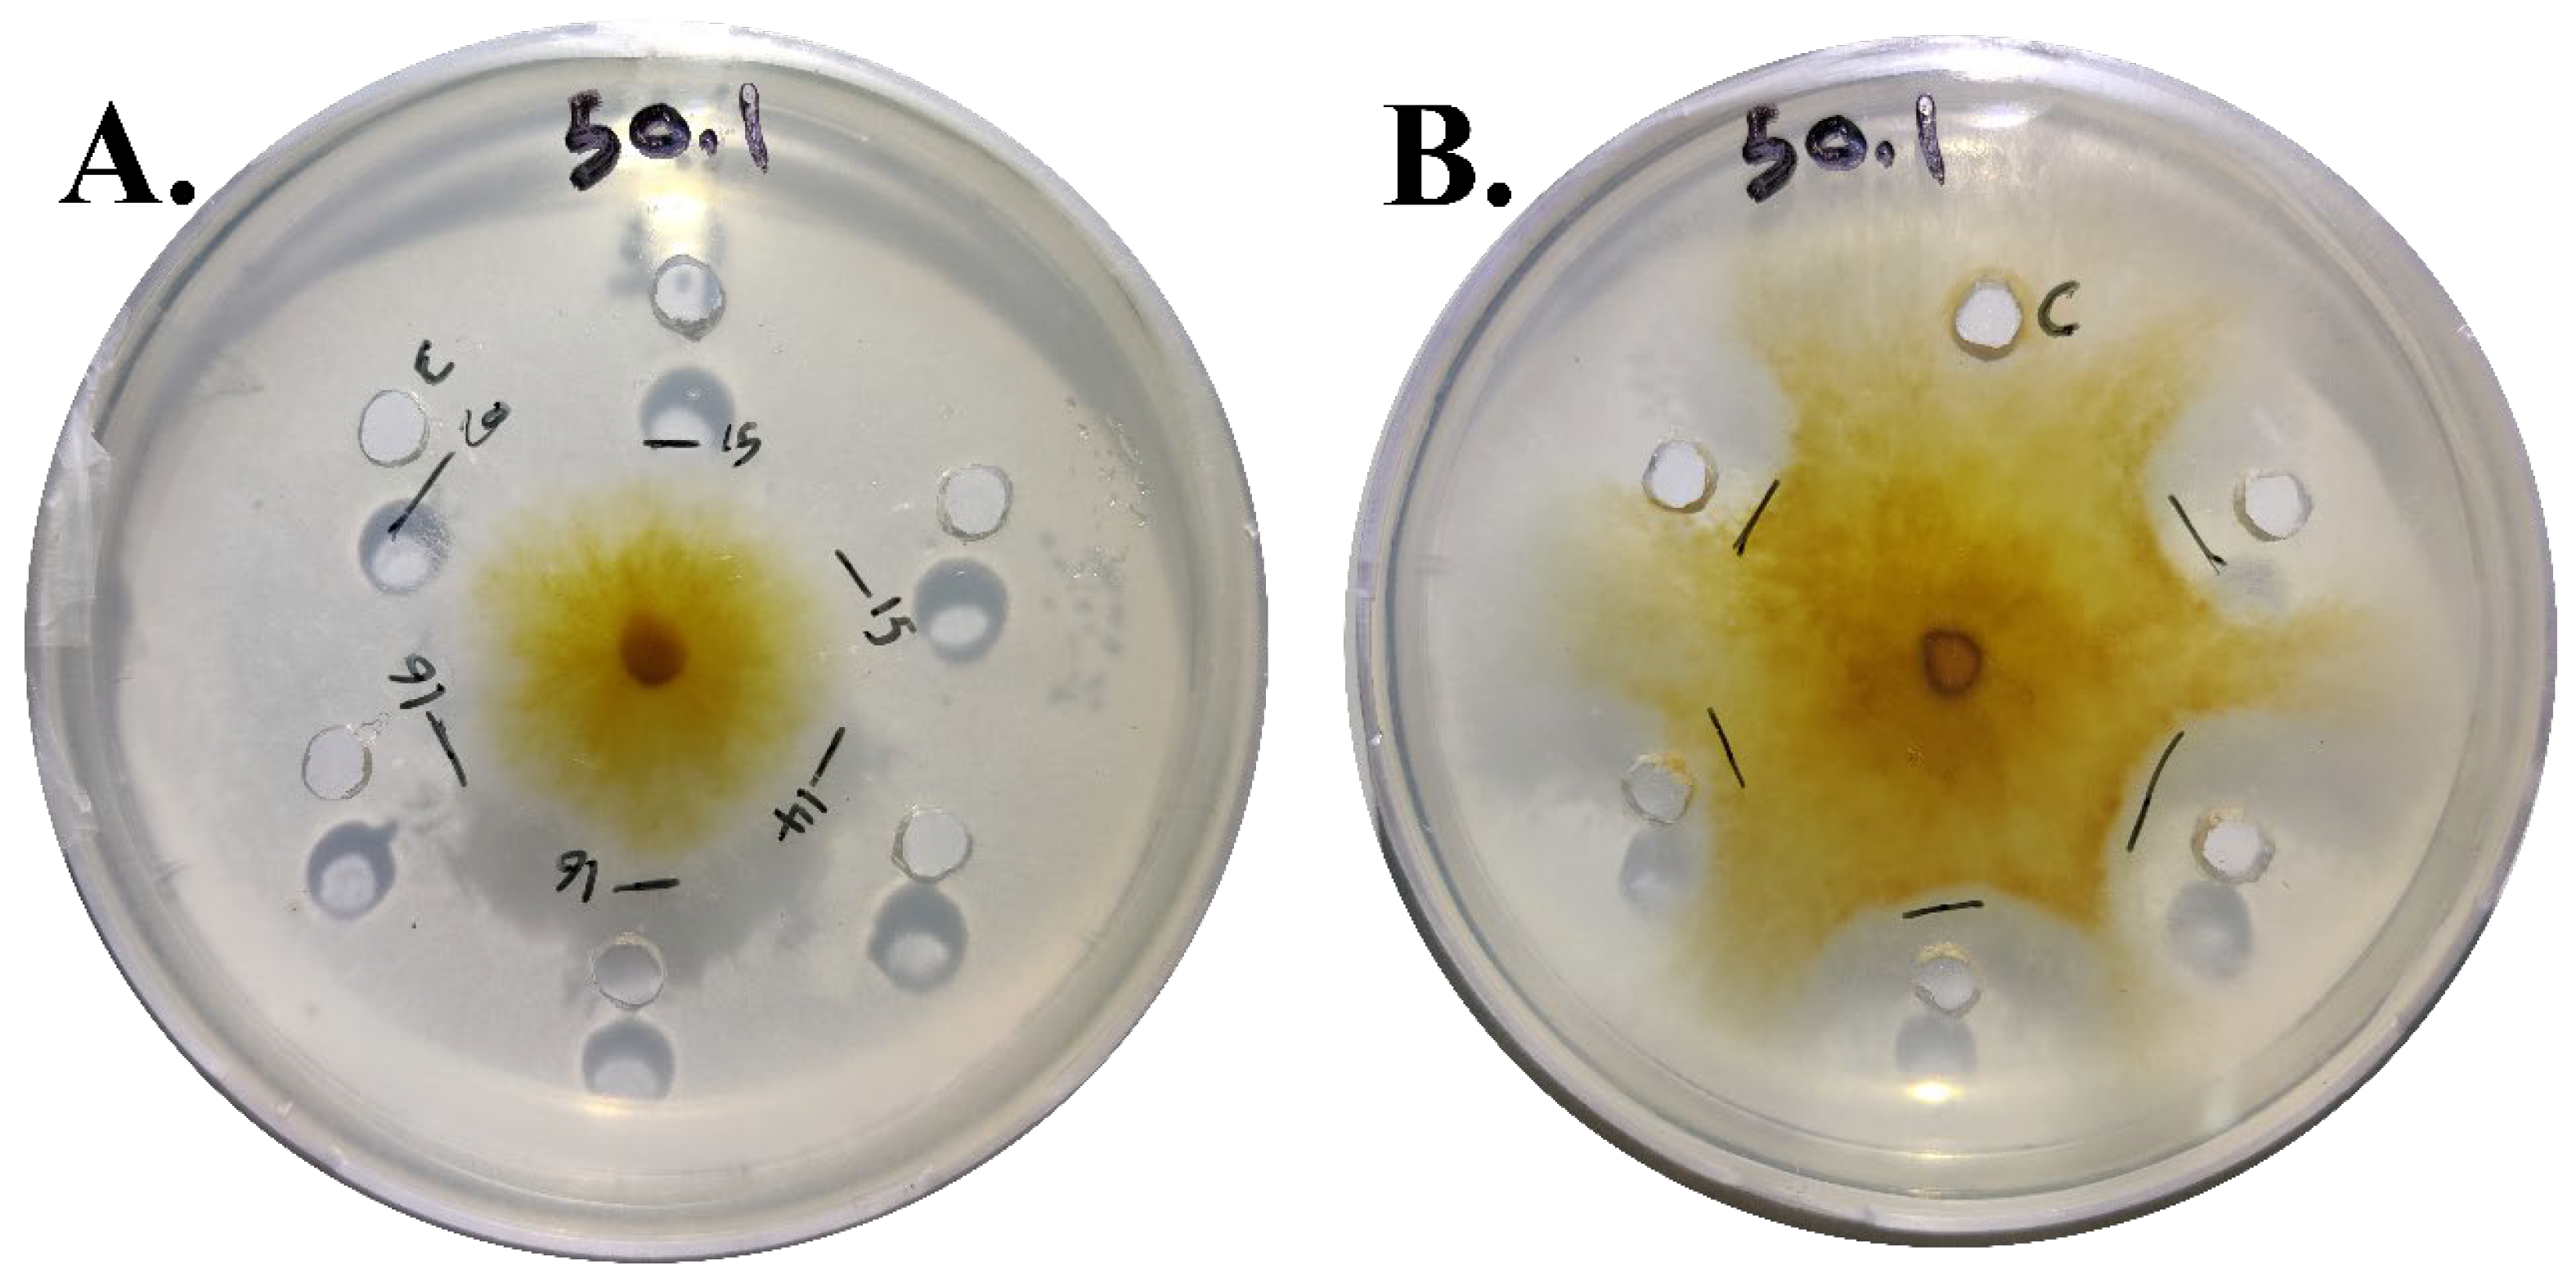
Agronomy 14 02912 g002

Evaluation of Endophytic Bacteria from Durum Wheat on Fusarium Root and Crown Rot Disease (Fusarium culmorum) Under Drought Stress
Abstract
1. Introduction
2. Materials and Methods
2.1. Durum Wheat Samples and Bacterial Endophyte Isolation
2.2. Evaluation of Antagonistic Effects of Endophytic Bacteria Against F. culmorum
2.2.1. Cross-Streak Method
2.2.2. Agar Well Diffusion Method
2.3. In Vitro Evaluation of the Growth of Bacterial Endophytes Under Drought Stress
2.4. Identification of Bacterial Isolates Using Molecular Methods
2.5. In Vitro Evaluation of Endophytic Bacteria Against F. culmorum
2.6. In Planta Evaluation of Endophytic Bacteria Effects
2.7. Data Collection and Statistical Analysis
3. Results
3.1. Bacterial Isolates
3.2. Antagonistic Effect of Bacterial Endophytes on F. culmorum
3.2.1. Cross-Streak Method
3.2.2. Agar Well Diffusion Method
3.3. Growth of Bacterial Endophytes Under Drought Stress Conditions
3.4. Bacterial Endophyte Identification
3.5. In Vitro Effects of Endophytic Bacteria on Seed Measurements Under Drought Stress and Crown Rot Infection (Seeds Experiment)
3.6. In Planta Effects of Endophytic Bacteria on Seedling Development Under Drought Stress and Crown Rot Infection (Seedlings Experiment)
3.6.1. UJ Experiment: Effects of Endophytic Bacteria on Seedling Development Under Drought Stress and Crown and Root Rot Infection
3.6.2. JUST Experiment: Effects of Endophytic Bacteria on Seedlings Development Under Drought Stress and Crown Rot Infection
4. Discussion
5. Conclusions
Supplementary Materials
Author Contributions
Funding
Data Availability Statement
Conflicts of Interest
References
- Sall, A.T.; Chiari, T.; Legesse, W.; Seid-Ahmed, K.; Ortiz, R.; Van Ginkel, M.; Bassi, F.M. Durum Wheat (Triticum durum Desf.): Origin, Cultivation and Potential Expansion in Sub-Saharan Africa. Agronomy 2019, 9, 263. [Google Scholar] [CrossRef]
- The International Wheat Council World Production Durum Wheat. In Proceedings of the International Wheat Council, London, UK, 1991.
- The Jordanian Ministry of Agriculture. Annual Statistical Report; The Jordanian Ministry of Agriculture: Amman, Jordan, 2022.
- Scherm, B.; Balmas, V.; Spanu, F.; Pani, G.; Delogu, G.; Pasquali, M.; Migheli, Q. Fusarium culmorum: Causal Agent of Foot and Root Rot and Head Blight on Wheat. Mol. Plant Pathol. 2013, 14, 323–341. [Google Scholar] [CrossRef] [PubMed]
- Moya-Elizondo, E.A. Fusarium Crown Rot Disease: Biology, Interactions, Management and Function as a Possible Sensor of Global Climate Change. Cienc. E Investig. Agrar. Rev. Latinoam. Cienc. Agric. 2013, 40, 235–252. [Google Scholar] [CrossRef]
- Bentley, A.R.; Cromey, M.G.; Farrokhi-Nejad, R.; Leslie, J.F.; Summerell, B.A.; Burgess, L.W. Fusarium Crown and Root Rot Pathogens Associated with Wheat and Grass Stem Bases on the South Island of New Zealand. Australas. Plant Pathol. 2006, 35, 495–502. [Google Scholar] [CrossRef]
- Hollaway, G.J.; Evans, M.L.; Wallwork, H.; Dyson, C.B.; Mckay, A.C. Yield Loss in Cereals, Caused by Fusarium culmorum and F. pseudograminearum, Is Related to Fungal DNA in Soil Prior to Planting, Rainfall, and Cereal Type. Plant Dis. 2013, 97, 977–982. [Google Scholar] [CrossRef] [PubMed]
- Poole, G.J.; Smiley, R.W.; Paulitz, T.C.; Walker, C.A.; Carter, A.H.; See, D.R.; Garland-Campbell, K. Identification of Quantitative Trait Loci (QTL) for Resistance to Fusarium Crown Rot (Fusarium pseudograminearum) in Multiple Assay Environments in the Pacific Northwestern US. Theor. Appl. Genet. 2012, 125, 91–107. [Google Scholar] [CrossRef]
- Pettitt, T.; Xu, X.; Parry, D. Association of Fusarium Species in the Wheat Stem Rot Complex. Eur. J. Plant Pathol. 2003, 109, 769–774. [Google Scholar] [CrossRef]
- Alananbeh, K.M.; Al-Abdallat, A.; Al-Hiary, H. First Report of Fusarium culmorum Causing Crown Rot on Wheat in Jordan. Plant Dis. 2024, 108, 799. [Google Scholar] [CrossRef]
- Vinocur, B.; Altman, A. Recent Advances in Engineering Plant Tolerance to Abiotic Stress: Achievements and Limitations. Curr. Opin. Biotechnol. 2005, 16, 123–132. [Google Scholar] [CrossRef]
- Parry, M.L. Climate Change 2007-Impacts, Adaptation and Vulnerability: Working Group II Contribution to the Fourth Assessment Report of the IPCC; Cambridge University Press: Cambridge, UK, 2007; Volume 4, ISBN 0521880106. [Google Scholar]
- Lastochkina, O.; Aliniaeifard, S.; Seifikalhor, M.; Yuldashev, R.; Pusenkova, L.; Garipova, S. Plant Growth-Promoting Bacteria: Biotic Strategy to Cope with Abiotic Stresses in Wheat. In Wheat Production in Changing Environments; Springer: Singapore, 2019; pp. 579–614. [Google Scholar] [CrossRef]
- Qtaishat, T.; El-Habbab, M.S.; Bumblauskas, D.P.; Tabieh, M. The Impact of Drought on Food Security and Sustainability in Jordan. GeoJournal 2022, 88, 1389–1400. [Google Scholar] [CrossRef]
- Compant, S.; Clément, C.; Sessitsch, A. Plant Growth-Promoting Bacteria in the Rhizo- and Endosphere of Plants: Their Role, Colonization, Mechanisms Involved and Prospects for Utilization. Soil. Biol. Biochem. 2010, 42, 669–678. [Google Scholar] [CrossRef]
- Johnston-Monje, D.; MN, R. Plant and Endophyte Relationships: Nutrient Management. Compr. Biotechnol. 2011, 4, 713–727. [Google Scholar] [CrossRef]
- White, J.F.; Kingsley, K.L.; Zhang, Q.; Verma, R.; Obi, N.; Dvinskikh, S.; Elmore, M.T.; Verma, S.K.; Gond, S.K.; Kowalski, K.P. Review: Endophytic Microbes and Their Potential Applications in Crop Management. Pest Manag. Sci. 2019, 75, 2558–2565. [Google Scholar] [CrossRef]
- Fadiji, A.E.; Babalola, O.O. Elucidating Mechanisms of Endophytes Used in Plant Protection and Other Bioactivities with Multifunctional Prospects. Front. Bioeng. Biotechnol. 2020, 8, 532550. [Google Scholar] [CrossRef]
- Kavamura, V.N.; Santos, S.N.; da Silva, J.L.; Parma, M.M.; Ávila, L.A.; Visconti, A.; Zucchi, T.D.; Taketani, R.G.; Andreote, F.D.; de Melo, I.S. Screening of Brazilian Cacti Rhizobacteria for Plant Growth Promotion Under Drought. Microbiol. Res. 2013, 168, 183–191. [Google Scholar] [CrossRef]
- Naveed, M.; Mitter, B.; Reichenauer, T.G.; Wieczorek, K.; Sessitsch, A. Increased Drought Stress Resilience of Maize Through Endophytic Colonization by Burkholderia phytofirmans PsJN and Enterobacter sp. FD17. Environ. Exp. Bot. 2014, 97, 30–39. [Google Scholar] [CrossRef]
- Lastochkina, O. Bacillus subtilis-Mediated Abiotic Stress Tolerance in Plants. Bacilli Agrobiotechnol. Phytostimul. Biocontrol 2019, 2, 97–133. [Google Scholar] [CrossRef]
- Al-Khawaldeh, M.M.; Araj, S.-E.; Alananbeh, K.M.; Al Antary, T.M. Wheat Cultivable Fungal Endophytes in Jordan. Fresenius Environ. Bull. 2020, 29, 1229–1240. [Google Scholar]
- Pan, D.; Mionetto, A.; Tiscornia, S.; Bettucci, L. Endophytic Bacteria from Wheat Grain as Biocontrol Agents of Fusarium graminearum and Deoxynivalenol Production in Wheat. Mycotoxin Res. 2015, 31, 137–143. [Google Scholar] [CrossRef]
- Lertcanawanichakul, M.; Sawangnop, S. A Comparison of Two Methods Used for Measuring the Antagonistic Activity of Bacillus Species. Walailak J. Sci. Technol. 2011, 5, 161–171. [Google Scholar]
- Magaldi, S.; Mata-Essayag, S.; de Capriles, C.H.; Perez, C.; Colella, M.T.; Olaizola, C.; Ontiveros, Y. Well Diffusion for Antifungal Susceptibility Testing. Int. J. Infect. Dis. 2004, 8, 39–45. [Google Scholar] [CrossRef] [PubMed]
- Meenakshi; Annapurna, K.; Govindasamy, V.; Ajit, V.; Choudhary, D.K. Mitigation of Drought Stress in Wheat Crop by Drought Tolerant Endophytic Bacterial Isolates. Vegetos 2019, 32, 486–493. [Google Scholar] [CrossRef]
- Michel, B.E.; Kaufmann, M.R. The Osmotic Potential of Polyethylene Glycol 6000. Plant Physiol. 1973, 51, 914–916. [Google Scholar] [CrossRef] [PubMed]
- Al-Karablieh, N.; Al-Shomali, I.; Al-Elaumi, L.; Hasan, K. Pseudomonas fluorescens NK4 Siderophore Promotes Plant Growth and Biocontrol in Cucumber. J. Appl. Microbiol. 2022, 133, 1414–1421. [Google Scholar] [CrossRef]
- Heuer, H.; Krsek, M.; Baker, P.; Smalla, K.; Wellington, E.M. Analysis of Actinomycete Communities by Specific Amplification of Genes Encoding 16S RRNA and Gel-Electrophoretic Separation in Denaturing Gradients. Appl. Environ. Microbiol. 1997, 63, 3233–3241. [Google Scholar] [CrossRef]
- Hall, T.A. BioEdit: A User-Friendly Biological Sequence Alignment Editor and Analysis Program for Windows 95/98/NT. In Proceedings of the Nucleic Acids Symposium Series, Oxford, UK, 1 November 1999; Volume 41, pp. 95–98. [Google Scholar]
- Al-Sayaydeh, R.; Shtaya, M.J.; Qubbaj, T.; Al-Rifaee, M.K.; Alabdallah, M.A.; Migdadi, O.; Gammoh, I.A.; Al-Abdallat, A.M. Performance and Stability Analysis of Selected Durum Wheat Genotypes Differing in Their Kernel Characteristics. Plants 2023, 12, 2664. [Google Scholar] [CrossRef]
- Leber, A.L. Preparation of Routine Media and Reagents Used in Antimicrobial Susceptibility Testing. Clin. Microbiol. Proced. Handb. 2016, 1–3. [Google Scholar]
- Falcäo, L.L.; Silva-Werneck, J.O.; Vilarinho, B.R.; da Silva, J.P.; Pomella, A.W.V.; Marcellino, L.H. Antimicrobial and Plant Growth-Promoting Properties of the Cacao Endophyte Bacillus subtilis ALB629. J. Appl. Microbiol. 2014, 116, 1584–1592. [Google Scholar] [CrossRef]
- Erginbas-Orakci, G.; Poole, G.; Nicol, J.M.; Paulitz, T.; Dababat, A.A.; Campbell, K. Assessment of Inoculation Methods to Identify Resistance to Fusarium Crown Rot in Wheat. J. Plant Dis. Prot. 2016, 123, 19–27. [Google Scholar] [CrossRef]
- Wildermuth, G.B.; McNamara, R.B. Testing Wheat Seedlings for Resistance to Crown Rot Caused by Fusarium graminearum Group 1. Plant Dis. 1994, 78, 949–953. [Google Scholar] [CrossRef]
- Joshi, B.; Chaudhary, A.; Singh, H.; Kumar, P.A. Prospective Evaluation of Individual and Consortia Plant Growth Promoting Rhizobacteria for Drought Stress Amelioration in Rice (Oryza sativa L.). Plant Soil 2020, 457, 225–240. [Google Scholar] [CrossRef]
- Steel, R.G.D.; Torrie, J.H. Principles and Procedures of Statistics, a Biometrical Approach 1981.
- Xu, X.; Cheng, Y.; Fang, Z.; Yin, J.; Shen, H.; Ma, D. Identification and Utilization of a New Bacillus amyloliquefaciens XY-1 Against Fusarium Head Blight. Front. Plant Sci. 2022, 13, 1055213. [Google Scholar] [CrossRef] [PubMed]
- Yi, Y.; Shan, Y.; Liu, S.; Yang, Y.; Liu, Y.; Yin, Y.; Hou, Z.; Luan, P.; Li, R. Antagonistic Strain Bacillus amyloliquefaciens XZ34-1 for Controlling Bipolaris sorokiniana and Promoting Growth in Wheat. Pathogens 2021, 10, 1526. [Google Scholar] [CrossRef] [PubMed]
- Tendulkar, S.R.; Saikumari, Y.K.; Patel, V.; Raghotama, S.; Munshi, T.K.; Balaram, P.; Chattoo, B.B. Isolation, Purification and Characterization of an Antifungal Molecule Produced by Bacillus licheniformis BC98, and Its Effect on Phytopathogen Magnaporthe Grisea. J. Appl. Microbiol. 2007, 103, 2331–2339. [Google Scholar] [CrossRef]
- Naing, K.W.; Anees, M.; Kim, S.J.; Nam, Y.; Kim, Y.C.; Kim, K.Y. Characterization of Antifungal Activity of Paenibacillus ehimensis KWN38 Against Soilborne Phytopathogenic Fungi Belonging to Various Taxonomic Groups. Ann. Microbiol. 2014, 64, 55–63. [Google Scholar] [CrossRef]
- Albdaiwi, R.N.; Khyami-Horani, H.; Ayad, J.Y.; Alananbeh, K.M.; Al-Sayaydeh, R. Isolation and Characterization of Halotolerant Plant Growth Promoting Rhizobacteria from Durum Wheat (Triticum turgidum Subsp. durum) Cultivated in Saline Areas of the Dead Sea Region. Front. Microbiol. 2019, 10, 1639. [Google Scholar]
- Tiwari, S.; Prasad, V.; Chauhan, P.S.; Lata, C. Bacillus amyloliquefaciens Confers Tolerance to Various Abiotic Stresses and Modulates Plant Response to Phytohormones Through Osmoprotection and Gene Expression Regulation in Rice. Front. Plant Sci. 2017, 8, 283109. [Google Scholar] [CrossRef]
- Gutiérrez-Mañero, F.J.; Ramos-Solano, B.; Probanza, A.; Mehouachi, J.; Tadeo, F.R.; Talon, M. The Plant-Growth-Promoting Rhizobacteria Bacillus pumilus and Bacillus licheniformis Produce High Amounts of Physiologically Active Gibberellins. Physiol. Plant. 2001, 111, 206–211. [Google Scholar] [CrossRef]
- Zhao, L.; Xu, Y.; Lai, X.-H.; Shan, C.; Deng, Z.; Ji, Y. Screening and Characterization of Endophytic Bacillus and Paenibacillus Strains from Medicinal Plant Lonicera japonica for Use as Potential Plant Growth Promoters. Braz. J. Microbiol. 2015, 46, 977–989. [Google Scholar] [CrossRef]
- Ji, C.; Wang, X.; Tian, H.; Hao, L.; Wang, C.; Zhou, Y.; Xu, R.; Song, X.; Liu, Y.; Du, J.; et al. Effects of Bacillus Methylotrophicus M4-1 on Physiological and Biochemical Traits of Wheat Under Salinity Stress. J. Appl. Microbiol. 2020, 129, 695–711. [Google Scholar] [CrossRef] [PubMed]

| Isolate | % Inhibition of Radial Mycelium Growth |
|---|---|
| 1 | 11.71 bc |
| 3 | 16.10 cde |
| 4 | 6.83 ab |
| 24 | 24.88 def |
| 25 | 29.27 f |
| 30 | 22.93 def |
| 31 | 16.54 cde |
| 32 | 14.37 bcd |
| 35 | 23.42 ef |
| 38 | 32.69 f |
| 50 | 18.05 cde |
| 60 | 15.13 b–e |
| Control | 0.00 a |
| LSD | 2.80 |
| Isolate No. | Identity | Percent Identity | Reference Accession |
|---|---|---|---|
| 4 | Bacillus amyloliquefaciens | 99.47% | OR150311.1 |
| 17 | Bacillus velezensis | 99.78% | ON560795.1 |
| 25 | Bacillus subtilis | 99.78% | MT040749.1 |
| 31 | Brevibacillus borstelensis | 99.46% | MT292327.1 |
| 32 | Niallia circulans (Bacillus circulans) | 99.24% | MK110353.1 |
| 37 | Bacillus licheniformis | 99.67% | OQ552687.1 |
| 38 | Bacillus licheniformis | 99.78% | MN117685.1 |
| 50 | Bacillus methylotrophicus | 99.24% | JN700089.1 |
| 52 | Bacillus velezensis | 99.47% | OR346369.1 |
| 60 | Paenibacillus ehimensis | 100.00% | MF692769.1 |
| Bacterial Isolate | Normal Watering | Drought Stress | ||
|---|---|---|---|---|
| Non-Inoculated | Inoculated F. culmorum | Non-Inoculated | Inoculated F. culmorum | |
| % Germination | ||||
| 32 | 93.34 ab | 86.67 abc | 60.00 def | 33.34 g |
| 38 | 90.00 abc | 90.00 abc | 73.34 c–f | 53.34 efg |
| 50 | 100.00 a | 93.34 ab | 70.00 b–e | 50.00 fg |
| 52 | 90.00 abc | 83.34 abc | 60.00 def | 73.34 b–e |
| 60 | 83.34 abc | 80.00 a–d | 73.34 b–e | 70.00 c–f |
| Control | 86.67 abc | 70.00 c–f | 83.34 abc | 60.00 def |
| LSD | 21.00 | |||
| Coleoptile length (cm) | ||||
| 32 | 10.26 bc | 8.56 def | 0.22 h | 0.10 h |
| 38 | 9.13 c–f | 8.15 ef | 0.22 h | 0.17 h |
| 50 | 11.03 b | 9.58 cd | 0.22 h | 0.15 h |
| 52 | 12.34 a | 9.23 cde | 0.18 h | 0.25 h |
| 60 | 13.48 a | 8.27 ef | 0.22 h | 0.21 h |
| Control | 7.93 fg | 6.75 g | 0.17 h | 0.12 h |
| LSD | 1.30 | |||
| Radicle length (cm) | ||||
| 32 | 12.28 bc | 12.82 abc | 1.78 ef | 2.10 ef |
| 38 | 12.47 bc | 11.96 c | 2.37 ef | 1.41 f |
| 50 | 14.59 ab | 15.19 a | 2.06 ef | 1.61 f |
| 52 | 13.84 abc | 13.04 abc | 1.58 f | 2.82 ef |
| 60 | 12.93 abc | 13.58 abc | 3.31 ef | 4.11 de |
| Control | 13.44 abc | 6.46 d | 2.98 ef | 2.06 ef |
| LSD | 2.44 | |||
| Seminal root number (SRN) | ||||
| 32 | 2.87 bc | 2.74 bc | 1.04 hij | 0.67 j |
| 38 | 3.10 ab | 2.70 bc | 1.54 f–i | 1.07 hij |
| 50 | 3.60 a | 2.54 bc | 1.40 f–i | 1.00 ij |
| 52 | 3.14 ab | 2.50 bcd | 1.20 g–j | 1.74 efg |
| 60 | 2.80 bc | 2.37 cde | 1.37 f–i | 1.40 f–i |
| Control | 2.67 bc | 1.87 def | 1.67 fgh | 1.54 f–i |
| LSD | 0.65 | |||
| Longest seminal root (cm) | ||||
| 32 | 11.77 a–d | 12.43 a–d | 1.06 fg | 0.10 g |
| 38 | 13.17 abc | 11.57 bcd | 1.65 fg | 0.84 fg |
| 50 | 13.74 ab | 13.84 a | 1.11 fg | 1.25 fg |
| 52 | 13.68 ab | 12.64 a–d | 1.50 fg | 2.48 f |
| 60 | 12.38 a–d | 11.00 cd | 1.84 fg | 2.28 fg |
| Control | 10.91 d | 8.66 e | 2.46 f | 1.94 fg |
| LSD | 2.19 | |||
| Isolate | Normal Irrigation | Drought | ||
|---|---|---|---|---|
| Non-Inoculated | Inoculated | Non-Inoculated | Inoculated | |
| Extended Length (cm) | ||||
| 32 | 54.62 a | 49.34 bc | 44.56 d–g | 44.34 d–g |
| 38 | 50.89 ab | 51.56 ab | 42.67 fgh | 41.78 gh |
| 50 | 50.89 ab | 46.67 cde | 44.89 d–g | 40.12 h |
| 52 | 51.56 ab | 51.00 ab | 44.89 d–g | 43.45 e–h |
| 60 | 51.34 ab | 49.67 bc | 46.56 c–f | 44.56 d–g |
| Control | 50.23 bc | 48.17 bcd | 41.56 gh | 43.67 e–h |
| LSD | 3.92 | |||
| Stem Length (cm) | ||||
| 32 | 37.17 a | 31.84 a–e | 30.99 b–e | 27.32 d–h |
| 38 | 33.65 abc | 35.44 ab | 25.18 fgh | 24.06 gh |
| 50 | 37.18 a | 27.25 d–h | 29.63 c–g | 28.09 c–h |
| 52 | 33.52 abc | 33.64 abc | 28.36 c–g | 31.55 a–e |
| 60 | 35.58 ab | 33.27 abc | 32.94 a–d | 30.72 b–f |
| Control | 27.06 e–h | 24.89 gh | 22.56 h | 26.17 e–h |
| LSD | 5.78 | |||
| Root Length (cm) | ||||
| 32 | 59.78 bc | 54.00 c–g | 49.45 f–j | 52.45 d–j |
| 38 | 56.67 b–e | 66.56 a | 50.00 e–j | 49.00 g–j |
| 50 | 54.89 b–g | 55.89 b–f | 50.12 e–j | 49.00 g–j |
| 52 | 61.23 ab | 53.34 c–h | 49.00 g–j | 47.00 h–k |
| 60 | 59.78 bc | 58.23 bcd | 52.34 d–j | 48.23 g–j |
| Control | 53.00 d–i | 45.78 jk | 46.56 ijk | 41.45 k |
| LSD | 6.72 | |||
| Fresh Weight (g) | ||||
| 32 | 6.56 b | 7.66 a | 4.81 cd | 4.35 cd |
| 38 | 7.17 ab | 7.26 ab | 4.16 d | 4.56 cd |
| 50 | 7.21 ab | 6.96 ab | 5.28 c | 4.50 cd |
| 52 | 7.34 ab | 7.25 ab | 4.42 cd | 5.32 c |
| 60 | 6.48 b | 7.21 ab | 4.02 d | 4.86 cd |
| Control | 6.88 ab | 7.32 ab | 4.85 cd | 4.90 cd |
| LSD | 1.1 | |||
| Dry Weight (g) | ||||
| 32 | 1.65 ab | 1.61 ab | 0.88 ef | 0.90 ef |
| 38 | 1.70 ab | 1.69 ab | 0.91 ef | 0.96 def |
| 50 | 1.80 a | 1.59 ab | 1.21 cd | 0.98 def |
| 52 | 1.74 ab | 1.72 ab | 1.07 de | 1.20 cd |
| 60 | 1.47 bc | 1.65 ab | 1.12 de | 1.08 de |
| Control | 1.69 ab | 1.50 b | 1.00 de | 0.72 f |
| LSD | 0.28 | |||
| Isolate | Normal Irrigation | Drought | ||
|---|---|---|---|---|
| Non-Inoculated | Inoculated | Non-Inoculated | Inoculated | |
| Extended Length (cm) | ||||
| 32 | 48.34 a–d | 48.45 a–d | 45.00 d–h | 43.89 e–i |
| 38 | 45.78 c–g | 48.23 a–d | 45.78 c–g | 40.67 i |
| 50 | 50.00 ab | 49.12 abc | 43.34 ghi | 46.23 c–g |
| 52 | 49.00 a–d | 49.23 abc | 51.56 a | 45.00 e–h |
| 60 | 46.89 b–f | 47.00 b–f | 48.34 a–d | 47.23 b–e |
| Control | 43.67 f–i | 41.56 hi | 34.28 j | 32.12 j |
| LSD | 0.35 | |||
| Stem Length (cm) | ||||
| 32 | 16.62 ab | 15.62 b–f | 13.84 g–k | 15.78 b–f |
| 38 | 15.00 c–h | 16.56 abc | 14.34 f–j | 13.56 h–k |
| 50 | 16.23 a–e | 15.34 b–g | 13.17 ijk | 14.50 f–j |
| 52 | 17.78 a | 16.34 a–d | 16.39 a–d | 13.95 g–k |
| 60 | 14.95 d–h | 15.73 b–f | 14.50 f–j | 14.67 e–i |
| Control | 13.67 h–k | 13.00 jkl | 12.50 kl | 11.45 l |
| LSD | 1.59 | |||
| Root Length (cm) | ||||
| 32 | 22.34 efg | 20.45 hij | 18.23 k | 21.67 fgh |
| 38 | 27.34 a | 22.34 efg | 18.45 k | 21.78 e–h |
| 50 | 25.00 b | 24.34 bcd | 20.89 gh | 21.34 fgh |
| 52 | 23.00 c–f | 22.78 def | 20.56 hi | 23.45 b–e |
| 60 | 28.67 a | 24.56 bc | 21.67 fgh | 23.00 c–f |
| Control | 22.34 efg | 19.12 ijk | 20.67 ghi | 18.78 jk |
| LSD | 1.73 | |||
| Fresh Weight (g) | ||||
| 32 | 10.56 abc | 8.95 def | 8.61 e–h | 7.55 hi |
| 38 | 9.03 def | 7.79 ghi | 6.94 ij | 6.13 jk |
| 50 | 10.85 ab | 9.55 cde | 8.79 efg | 8.12 fgh |
| 52 | 11.51 a | 9.92 bcd | 8.83 d–g | 8.58 e–h |
| 60 | 11.29 a | 10.18 bc | 8.79 efg | 8.19 fgh |
| Control | 8.19 fgh | 6.90 ij | 5.31 kl | 5.04 l |
| LSD | 1.09 | |||
| Dry Weight (g) | ||||
| 32 | 2.90 abc | 2.54 a–g | 1.83 hi | 2.60 a–f |
| 38 | 2.66 a–f | 2.04 f–i | 2.06 f–i | 1.91 ghi |
| 50 | 3.08 a | 2.03 f–i | 2.10 e–i | 2.21 d–i |
| 52 | 3.01 ab | 2.83 a–d | 2.77 a–e | 2.41 a–h |
| 60 | 2.76 a–e | 2.87 a–d | 2.23 c–i | 2.51 a–h |
| Control | 2.39 b–h | 2.03 f–i | 1.59 i | 1.56 i |
| LSD | 0.682 | |||
Disclaimer/Publisher’s Note: The statements, opinions and data contained in all publications are solely those of the individual author(s) and contributor(s) and not of MDPI and/or the editor(s). MDPI and/or the editor(s) disclaim responsibility for any injury to people or property resulting from any ideas, methods, instructions or products referred to in the content. |
© 2024 by the authors. Licensee MDPI, Basel, Switzerland. This article is an open access article distributed under the terms and conditions of the Creative Commons Attribution (CC BY) license (https://creativecommons.org/licenses/by/4.0/).
Share and Cite
Abu El Samen, F.M.; Alsawalha, I.; Alananbeh, K.M.; Al-Karablieh, N.; Al-Abdallat, A.M. Evaluation of Endophytic Bacteria from Durum Wheat on Fusarium Root and Crown Rot Disease (Fusarium culmorum) Under Drought Stress. Agronomy 2024, 14, 2912. https://doi.org/10.3390/agronomy14122912
Abu El Samen FM, Alsawalha I, Alananbeh KM, Al-Karablieh N, Al-Abdallat AM. Evaluation of Endophytic Bacteria from Durum Wheat on Fusarium Root and Crown Rot Disease (Fusarium culmorum) Under Drought Stress. Agronomy. 2024; 14(12):2912. https://doi.org/10.3390/agronomy14122912
Chicago/Turabian StyleAbu El Samen, Firas M., Imran Alsawalha, Kholoud M. Alananbeh, Nehaya Al-Karablieh, and Ayed M. Al-Abdallat. 2024. "Evaluation of Endophytic Bacteria from Durum Wheat on Fusarium Root and Crown Rot Disease (Fusarium culmorum) Under Drought Stress" Agronomy 14, no. 12: 2912. https://doi.org/10.3390/agronomy14122912
APA StyleAbu El Samen, F. M., Alsawalha, I., Alananbeh, K. M., Al-Karablieh, N., & Al-Abdallat, A. M. (2024). Evaluation of Endophytic Bacteria from Durum Wheat on Fusarium Root and Crown Rot Disease (Fusarium culmorum) Under Drought Stress. Agronomy, 14(12), 2912. https://doi.org/10.3390/agronomy14122912

